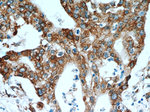
P4HA2 Antibody in Immunohistochemistry (Paraffin) (IHC (P))

Search
Proteintech
P4HA2 Polyclonal Antibody
{{$productOrderCtrl.translations['antibody.pdp.commerceCard.promotion.promotions']}}
{{$productOrderCtrl.translations['antibody.pdp.commerceCard.promotion.viewpromo']}}
{{$productOrderCtrl.translations['antibody.pdp.commerceCard.promotion.promocode']}}: {{promo.promoCode}} {{promo.promoTitle}} {{promo.promoDescription}}. {{$productOrderCtrl.translations['antibody.pdp.commerceCard.promotion.learnmore']}}
产品信息
13759-1-AP
种属反应
已发表种属
宿主/亚型
分类
类型
抗原
偶联物
形式
浓度
规格
纯化类型
保存液
内含物
保存条件
运输条件
产品详细信息
Immunogen sequence: HTVLWMEQV LKQLDAGEEA TTTKSQVLDY LSYAVFQLGD LHRALELTRR LLSLDPSHER AGGNLRYFEQ LLEEEREKTL TNQTEAELAT PEGIYERPVD YLPERDVYES LCRGEGVKLT PRRQKRLFCR YHHGNRAPQL LIAPFKEEDE WDSPHIVRYY DVMSDEEIER IKEIAKPKLA RATVRDPKTG VLTVASYRVS KSSWLEEDDD PVVARVNRRM QHITGLTVKT AELLQVANYG VGGQYEPHFD FSRRPFDSGL KTEGNRLATF LNYMSDVEAG GATVFPDLGA AIWPKKGTAV FWYNLLRSGE GDYRTRHAAC PVLVGCKWVS NKWFHERGQE FLRPCGSTEV D (184-533 aa encoded by BC035813)
靶标信息
This gene encodes a component of prolyl 4-hydroxylase, a key enzyme in collagen synthesis composed of two identical alpha subunits and two beta subunits. The encoded protein is one of several different types of alpha subunits and provides the major part of the catalytic site of the active enzyme. In collagen and related proteins, prolyl 4-hydroxylase catalyzes the formation of 4-hydroxyproline that is essential to the proper three-dimensional folding of newly synthesized procollagen chains. Alternatively spliced transcript variants encoding different isoforms have been described.
仅用于科研。不用于诊断过程。未经明确授权不得转售。
生物信息学
蛋白别名: 4-PH alpha 2; 4-PH alpha-2; 4PHalpha2; C-P4Halpha(II); collagen prolyl 4-hydroxylase alpha(II); lncRNA promotes epithelial-mesenchymal transition; procollagen-proline, 2-oxoglutarate 4-dioxygenase (proline 4-hydroxylase), alpha polypeptide II; Procollagen-proline,2-oxoglutarate-4-dioxygenase subunit alpha-2; Prolyl 4-hydroxylase subunit alpha-2; prolyl 4-hydroxylase, alpha polypeptide II
基因别名: lncRNA-PE; MYP25; P4HA2; UNQ290/PRO330
UniProt ID: (Human) O15460
Entrez Gene ID: (Human) 8974